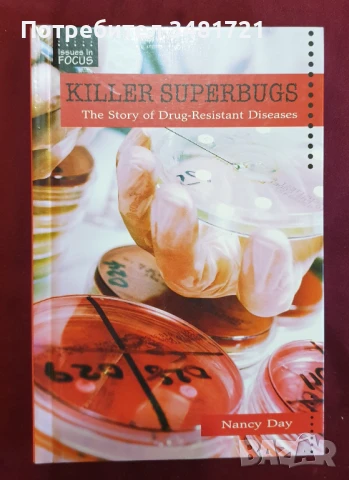
Микро-убийци. Историята на неподдаващи се на лечение болести / Killer Superbugs. The Story of Drug-R, снимка 1

Микро-убийци. Историята на неподдаващи се на лечение болести / Killer Superbugs. The Story of Drug-R → Обява 50499189
Микро-убийци. Историята на неподдаващи се на лечение болести / Killer Superbugs. The Story of Drug-R, 6,65 €
гр. Пловдив, Център
Изтекла/Деактивирана на 24 октомври 2025г. в 14:05 ч.
Killer Superbugs. The Story of Drug-Resistant Diseases
Отлично запазена, твърди корици, 128 страници, английски език.
Книгата представя историята на това как някои протозои и бактерии са станали резистентни към съвременните антибиотици, водейки до повторна поява на сериозни здравословни проблеми и фатални заболявания, в днешния свят.
В наши дни, човечеството консумира над 2235 милиона дози антибиотици на година. Те са често предписвани и на деца, особено при ушни инфекции. Нанси Дей разказва каква е историята на откриването и създаването на антибиотиците и как бактерии все по-често развиват резистентност към тях. Представена е също нелеката борба, която много доктори по света водят срещу масовото и неумерено предписване на антибиотици, особено при заболявания, при които те на практика имат почти нулев положителен ефект.
Преглеждания: 34
Още обяви в Bazar.BG
Вижте подобни обяви:
Вход
Регистрация
Влез в профила си или се регистрирай, за да не губиш наблюдаваните обяви, търсенията си и следваните потребители – ще ги имаш навсякъде с теб.
Вход/Регистрация